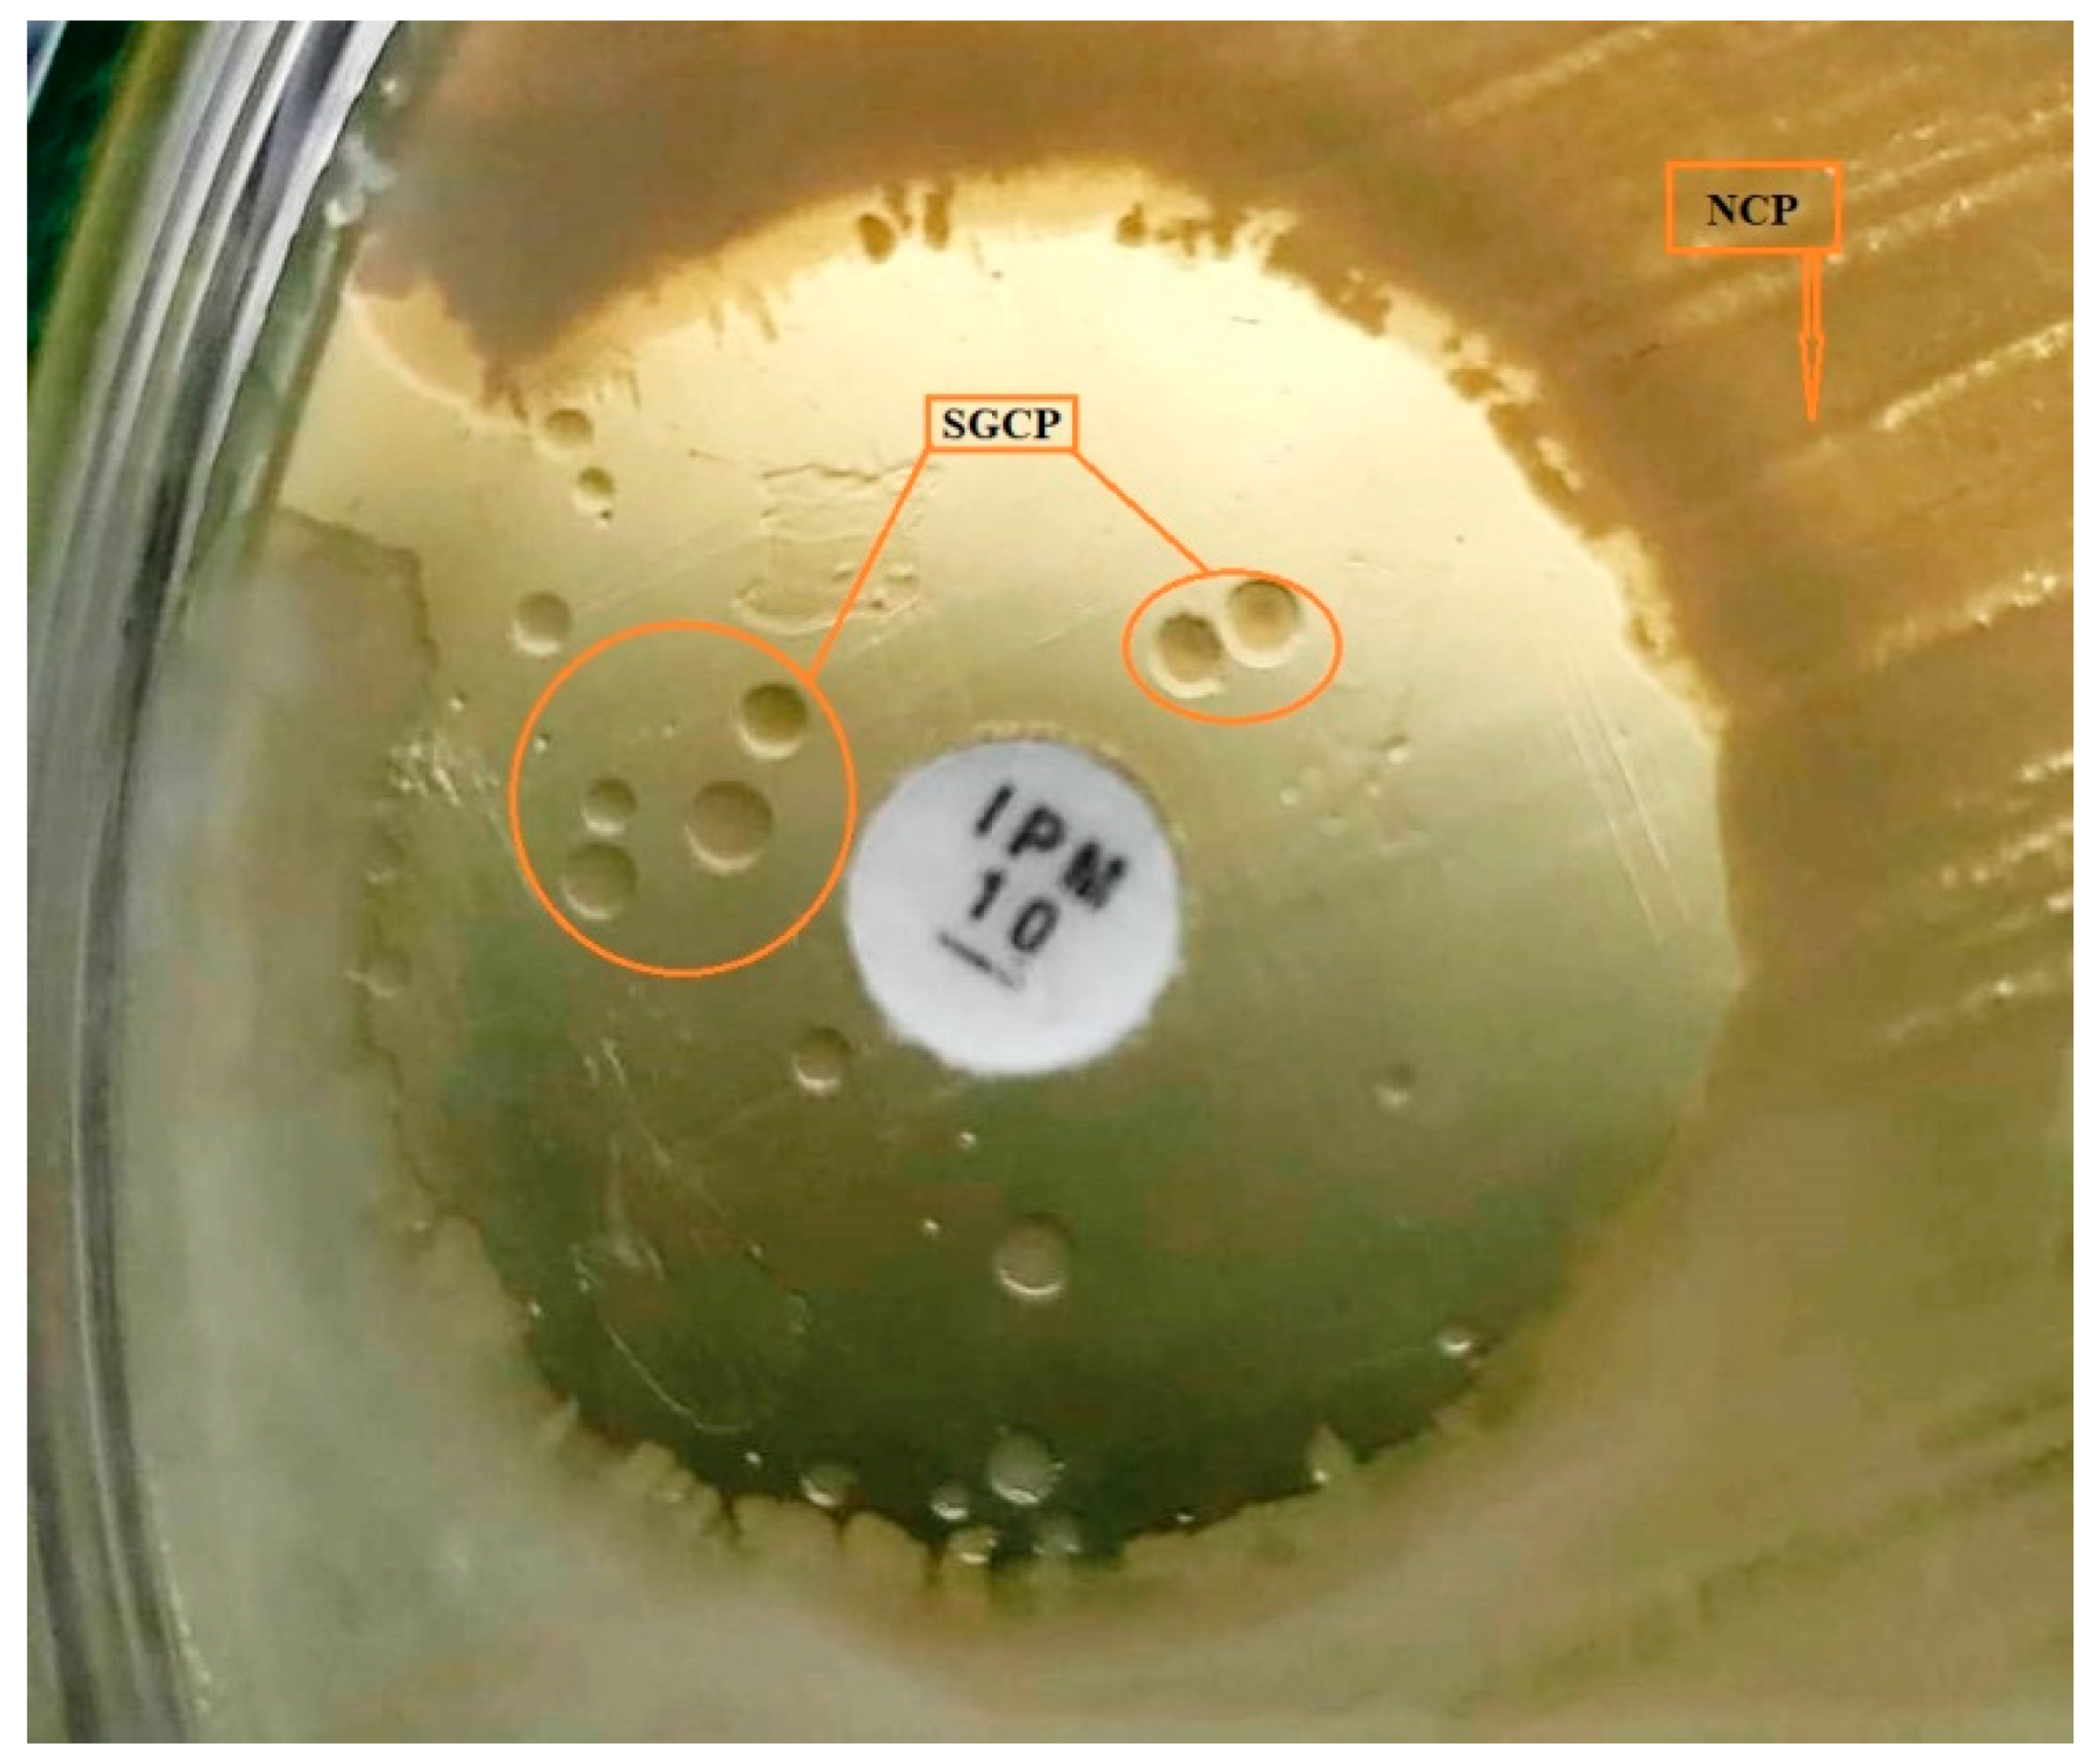
Applsci 12 08357 g001

Pseudomonas aeruginosa Response to Acidic Stress and Imipenem Resistance
Abstract
1. Introduction
2. Materials and Methods
2.1. Bacterial Strains Isolation and Confirmation
- N = Number of colonies/mL
- Σc = sum of all colonies on all plates counted
- = number of plates in the first dilution counted
- = number of plates in the second dilution counted
- = dilution from which the first counts were obtained
- oprI-F-5′-ATGAACAACGTTCTGAAATTCTCTGCT-3′
- oprI-R-5′-CTTGCGGCTGGCTTTTTCCAG-3′
- oprL-F-5′-ATGGAAATGCTGAAATTCGGC-3′
- oprL-R-5′-CTTCTTCAGCTCGACGCGACG-3′
2.2. Antibiotic Sensitivity Testing (Kirby Bauer-Disk Diffusion Method)
2.3. MIC Determination for Imipenem
2.4. Biofilm Formation Assay
2.5. Population Analysis Assay
2.6. Small Colony Variant (SCV) Characterization
2.7. Reversion
2.8. Scanning Electron Microscopy (SEM)
2.9. Statistical Analysis
3. Results
3.1. Effect of pH and Time on P. aeruginosa Biofilm Population
3.2. Antibiotic Sensitivity
3.3. Biofilm Formation
4. Discussions
5. Conclusions
Author Contributions
Funding
Institutional Review Board Statement
Informed Consent Statement
Data Availability Statement
Acknowledgments
Conflicts of Interest
References
- Bitew, A. High prevalence of multi-drug resistance and extended spectrum beta lactamase production in non-fermenting gram-negative bacilli in Ethiopia. Infect. Dis. Res. Treat. 2019, 12. [Google Scholar] [CrossRef] [PubMed]
- Rehman, A.; Patrick, W.M.; Lamont, I.L. Mechanisms of ciprofloxacin resistance in Pseudomonas aeruginosa: New approaches to an old problem. J. Med. Microbiol. 2019, 68, 1–10. [Google Scholar] [CrossRef] [PubMed]
- Holban, A.-M.; Chifiriuc, M.C.; Cotar, A.I.; Bleotu, C.; Grumezescu, A.M.; Banu, O.; Lazar, V. Virulence markers in Pseudomonas aeruginosa isolates from hospital acquired infections occurred in patients with underlying cardiovascular disease. Rom. Biotechnol. Lett. 2013, 18, 8843–8854. Available online: https://e-repository.org/rbl/vol.18/iss.6/13.pdf (accessed on 8 May 2022).
- Wang, C.; Ye, Q.; Jiang, A.; Zhang, J.; Shang, Y.; Li, F.; Zhou, B.; Xiang, X.; Gu, Q.; Pang, R.; et al. Pseudomonas aeruginosa Detection Using Conventional PCR and Quantitative Real-Time PCR Based on Species-Specific Novel Gene Target Identified by Pangenome Analysis. Front. Microbiol. 2022, 13, 820431. [Google Scholar] [CrossRef]
- Eckmanns, T.; Oppert, M.; Martin, M.; Amorosa, R.; Zuschneid, I.; Frei, U.; Rüden, H.; Weist, K. An outbreak of hospital-acquired Pseudomonas aeruginosa infection caused by contaminated bottled water in intensive care units. Clin. Microbiol. Infect. 2008, 14, 454–458. [Google Scholar] [CrossRef] [PubMed]
- Khan, N.H.; Ahsan, M.; Taylor, W.D.; Kogure, K. Culturability and survival of marine, freshwater and clinical Pseudomonas aeruginosa. Microbes Environ. 2009, 25, 266–274. [Google Scholar] [CrossRef]
- Allydice-Francis, K.; Brown, P.D. Diversity of antimicrobial resistance and virulence determinants in Pseudomonas aeruginosa associated with fresh vegetables. Int. J. Microbiol. 2012, 2012, 426241. [Google Scholar] [CrossRef]
- Haileselassie, M.; Taddele, H.; Adhana, K.; Kalayou, S. Food safety knowledge and practices of abattoir and butchery shops and the microbial profile of meat in Mekelle City, Ethiopia. Asian Pac. J. Trop. Biomed. 2013, 3, 407–412. [Google Scholar] [CrossRef]
- Mikkelsen, H.; Sivaneson, M.; Filloux, A. Key two-component regulatory systems that control biofilm formation in Pseudomonas aeruginosa. Environ. Microbiol. 2011, 13, 1666–1681. [Google Scholar] [CrossRef]
- Mah, T.-F.; Pitts, B.; Pellock, B.; Walker, G.C.; Stewart, P.S.; O’Toole, G.A. A genetic basis for Pseudomonas aeruginosa biofilm antibiotic resistance. Nature 2003, 426, 306–310. [Google Scholar] [CrossRef]
- Ma, L.; Conover, M.; Lu, H.; Parsek, M.R.; Bayles, K.; Wozniak, D.J. Assembly and development of the Pseudomonas aeruginosa biofilm matrix. PLoS Pathog. 2009, 5, e1000354. [Google Scholar] [CrossRef] [PubMed]
- Jennings, L.K.; Storek, K.M.; Ledvina, H.E.; Coulon, C.; Marmont, L.S.; Sadovskaya, I.; Secor, P.R.; Tseng, B.S.; Scian, M.; Filloux, A. Pel is a cationic exopolysaccharide that cross-links extracellular DNA in the Pseudomonas aeruginosa biofilm matrix. Proc. Natl. Acad. Sci. USA 2015, 112, 11353–11358. [Google Scholar] [CrossRef]
- Meirelles, L.A.; Newman, D.K. Both toxic and beneficial effects of pyocyanin contribute to the lifecycle of Pseudomonas aeruginosa. Mol. Microbiol. 2018, 110, 995–1010. [Google Scholar] [CrossRef]
- Wickramasinghe, N.N.; Hlaing, M.M.; Ravensdale, J.T.; Coorey, R.; Chandry, P.S.; Dykes, G.A. Characterization of the biofilm matrix composition of psychrotrophic, meat spoilage pseudomonads. Sci. Rep. 2020, 10, 16457. [Google Scholar] [CrossRef]
- Chan, M.W.H.; Mirani, Z.A.; Khan, M.N.; Ali, A.; Khan, A.B.; Rauf, N. Isolation and characterization of small colony variants of Staphylococcus aureus in various food samples. Biocatal. Agric. Biotechnol. 2021, 35, 102097. [Google Scholar] [CrossRef]
- Berlanga, M.; Guerrero, R. Living together in biofilms: The microbial cell factory and its biotechnological implications. Microb. Cell Factories 2016, 15, 165. [Google Scholar] [CrossRef] [PubMed]
- Costerton, J.W.; Cheng, K.; Geesey, G.G.; Ladd, T.I.; Nickel, J.C.; Dasgupta, M.; Marrie, T.J. Bacterial biofilms in nature and disease. Annu. Rev. Microbiol. 1987, 41, 435–464. [Google Scholar] [CrossRef]
- Moradali, M.F.; Ghods, S.; Rehm, B.H. Pseudomonas aeruginosa lifestyle: A paradigm for adaptation, survival and persistence. Front. Cell. Infect. Microbiol. 2017, 7, 39. [Google Scholar] [CrossRef]
- Häußler, S.; Tümmler, B.; Weißbrodt, H.; Rohde, M.; Steinmetz, I. Small-colony variants of Pseudomonas aeruginosa in cystic fibrosis. Arch. Clin. Infect. Dis. 1999, 29, 621–625. [Google Scholar] [CrossRef]
- Starkey, M.; Hickman, J.H.; Ma, L.; Zhang, N.; De Long, S.; Hinz, A.; Palacios, S.; Manoil, C.; Kirisits, M.J.; Starner, T.D. Pseudomonas aeruginosa rugose small-colony variants have adaptations that likely promote persistence in the cystic fibrosis lung. J. Bacteriol. Res. 2009, 191, 3492–3503. [Google Scholar] [CrossRef]
- Wilton, M.; Charron-Mazenod, L.; Moore, R.; Lewenza, S. Extracellular DNA acidifies biofilms and induces aminoglycoside resistance in Pseudomonas aeruginosa. Antimicrob. Agents Chemother. 2016, 60, 544–553. [Google Scholar] [CrossRef] [PubMed]
- Gholami, A.; Majidpour, A.; Talebi-Taher, M.; Boustanshenas, M.; Adabi, M. PCR-based assay for the rapid and precise distinction of Pseudomonas aeruginosa from other Pseudomonas species recovered from burns patients. J. Prev. Med. Hyg. 2016, 57, E81. [Google Scholar] [CrossRef] [PubMed]
- CLSI. Performance Standards for Antimicrobial Susceptibility Testing, 30th ed.; CLSI Supplement M100; Clinical and Laboratory Standard Institute: Wayne, PA, USA, 2020. [Google Scholar]
- O’Toole, G.A. Microtiter dish biofilm formation assay. J. Vis. Exp. 2011, 47, e2437. [Google Scholar] [CrossRef] [PubMed]
- Ullah, A.; Yin, X.; Wang, F.; Xu, B.; Mirani, Z.A.; Xu, B.; Chan, M.W.H.; Ali, A.; Usman, M.; Ali, N. Biosynthesis of Selenium Nanoparticles (via Bacillus subtilis BSN313), and Their Isolation, Characterization, and Bioactivities. Molecules 2021, 26, 5559. [Google Scholar] [CrossRef]
- Crompton, M.J.; Dunstan, R.H.; Macdonald, M.M.; Gottfries, J.; von Eiff, C.; Roberts, T.K. Small changes in environmental parameters lead to alterations in antibiotic resistance, cell morphology and membrane fatty acid composition in Staphylococcus lugdunensis. PLoS ONE 2014, 9, e92296. [Google Scholar] [CrossRef] [PubMed]
- Xu, Z.; Xie, J.; Soteyome, T.; Peters, B.M.; Shirtliff, M.E.; Liu, J.; Harro, J.M. Polymicrobial interaction and biofilms between Staphylococcus aureus and Pseudomonas aeruginosa: An underestimated concern in food safety. Curr. Opin. Food Sci. 2019, 26, 57–64. [Google Scholar] [CrossRef]
- Aman, M.; Aneeqha, N.; Bristi, K.; Deeksha, J.; Afza, N.; Sindhuja, V.; Shastry, R.P. Lactic acid bacteria inhibits quorum sensing and biofilm formation of Pseudomonas aeruginosa strain JUPG01 isolated from rancid butter. Biocatal. Agric. Biotechnol. 2021, 36, 102115. [Google Scholar] [CrossRef]
- Broughall, J.; Anslow, P.; Kilsby, D. Hazard analysis applied to microbial growth in foods: Development of mathematical models describing the effect of water activity. J. Appl. Bacteriol. 1983, 55, 101–110. [Google Scholar] [CrossRef]
- Cotter, P.D.; Hill, C. Surviving the acid test: Responses of gram-positive bacteria to low pH. Microbiol. Mol. Biol. Rev. 2003, 67, 429–453. [Google Scholar] [CrossRef]
- Kaprelyants, A.S.; Gottschal, J.C.; Kell, D.B. Dormancy in non-sporulating bacteria. FEMS Microbiol. Lett. 1993, 104, 271–285. [Google Scholar] [CrossRef]
- Møretrø, T.; Langsrud, S. Residential bacteria on surfaces in the food industry and their implications for food safety and quality. Rev. Food Sci. Food Saf. 2017, 16, 1022–1041. [Google Scholar] [CrossRef]
- Jefferson, K.K. What drives bacteria to produce a biofilm? FEMS Microbiol. Lett. 2004, 236, 163–173. [Google Scholar] [CrossRef] [PubMed]
- Kumar, A.; Alam, A.; Rani, M.; Ehtesham, N.Z.; Hasnain, S.E. Biofilms: Survival and defense strategy for pathogens. Int. J. Med. Microbiol. 2017, 307, 481–489. [Google Scholar] [CrossRef] [PubMed]
- Fennelly, K.P.; Ojano-Dirain, C.; Yang, Q.; Liu, L.; Lu, L.; Progulske-Fox, A.; Wang, G.P.; Antonelli, P.; Schultz, G. Biofilm formation by Mycobacterium abscessus in a lung cavity. Am. J. Respir. Crit. Care Med. 2016, 193, 692–693. [Google Scholar] [CrossRef]
- Fey, P.D.; Olson, M.E. Current concepts in biofilm formation of Staphylococcus epidermidis. Future Microbiol. 2010, 5, 917–933. [Google Scholar] [CrossRef]
- Kornspan, J.D.; Tarshis, M.; Rottem, S. Adhesion and biofilm formation of Mycoplasma pneumoniae on an abiotic surface. Arch. Microbiol. 2011, 193, 833–836. [Google Scholar] [CrossRef]
- Pang, J.M.; Layre, E.; Sweet, L.; Sherrid, A.; Moody, D.B.; Ojha, A.; Sherman, D.R. The polyketide Pks1 contributes to biofilm formation in Mycobacterium tuberculosis. J. Bacteriol. Res. 2012, 194, 715–721. [Google Scholar] [CrossRef] [PubMed]
- Ramage, G.; Walle, K.V.; Wickes, B.L.; Lopez-Ribot, J.L. Characteristics of biofilm formation by Candida albicans. Rev. Iberoam. Micol. 2001, 18, 163–170. Available online: https://pubmed.ncbi.nlm.nih.gov/15496122/ (accessed on 17 August 2022). [PubMed]
- Davey, M.E.; O’Toole, G.A. Microbial biofilms: From ecology to molecular genetics. Microbiol. Mol. Biol. Rev. 2000, 64, 847–867. [Google Scholar] [CrossRef]
- Shevchenko, S.N.; Burkhardt, M.; Sheval, E.V.; Natashina, U.A.; Grosse, C.; Nikolaev, A.L.; Gopin, A.V.; Neugebauer, U.; Kudryavtsev, A.A.; Sivakov, V. Antimicrobial effect of biocompatible silicon nanoparticles activated using therapeutic ultrasound. Langmuir 2017, 33, 2603–2609. [Google Scholar] [CrossRef]
- Frimmersdorf, E.; Horatzek, S.; Pelnikevich, A.; Wiehlmann, L.; Schomburg, D. How Pseudomonas aeruginosa adapts to various environments: A metabolomic approach. Environ. Microbiol. 2010, 12, 1734–1747. [Google Scholar] [CrossRef] [PubMed]
- Gray, D.A.; Dugar, G.; Gamba, P.; Strahl, H.; Jonker, M.J.; Hamoen, L.W. Extreme slow growth as alternative strategy to survive deep starvation in bacteria. Nat. Commun. 2019, 10, 890. [Google Scholar] [CrossRef]
- Moriarty, T.; Elborn, J.; Tunney, M. Effect of pH on the antimicrobial susceptibility of planktonic and biofilm-grown clinical Pseudomonas aeruginosa isolates. Br. J. Biomed. Sci. 2007, 64, 101–104. [Google Scholar] [CrossRef] [PubMed]
- Lewenza, S.; Abboud, J.; Poon, K.; Kobryn, M.; Humplik, I.; Bell, J.R.; Mardan, L.; Reckseidler-Zenteno, S. Pseudomonas aeruginosa displays a dormancy phenotype during long-term survival in water. PLoS ONE 2018, 13, e0198384. [Google Scholar] [CrossRef] [PubMed]
- Workentine, M.L.; Sibley, C.D.; Glezerson, B.; Purighalla, S.; Norgaard-Gron, J.C.; Parkins, M.D.; Rabin, H.R.; Surette, M.G. Phenotypic heterogeneity of Pseudomonas aeruginosa populations in a cystic fibrosis patient. PLoS ONE 2013, 8, e60225. [Google Scholar] [CrossRef]
- Lewis, K. Persister cells, dormancy and infectious disease. Nat. Rev. Microbiol. 2007, 5, 48–56. [Google Scholar] [CrossRef]
- Huang, S.-H.; Chen, Y.-C.; Chuang, Y.-C.; Chiu, S.-K.; Fung, C.-P.; Lu, P.-L.; Wang, L.-S.; Wu, T.-L.; Wang, J.-T. Prevalence of vancomycin-intermediate Staphylococcus aureus (VISA) and heterogeneous VISA among methicillin-resistant S. aureus with high vancomycin minimal inhibitory concentrations in Taiwan: A multicenter surveillance study, 2012–2013. J. Microbiol. Immunol. Infect. 2016, 49, 701–707. [Google Scholar] [CrossRef][Green Version]
- Quale, J.; Shah, N.; Kelly, P.; Babu, E.; Backer, M.; Rosas-Garcia, G.; Salamera, J.; George, A.; Bratu, S.; Landman, D. Activity of polymyxin B and the novel polymyxin analogue CB-182,804 against contemporary Gram-negative pathogens in New York City. Microb. Drug Resist. 2012, 18, 132–136. [Google Scholar] [CrossRef]
- Lennon, J.T.; Jones, S.E. Microbial seed banks: The ecological and evolutionary implications of dormancy. Nat. Rev. Microbiol. 2011, 9, 119–130. [Google Scholar] [CrossRef]
- Xu, Y.; Zheng, X.; Zeng, W.; Chen, T.; Liao, W.; Qian, J.; Lin, J.; Zhou, C.; Tian, X.; Cao, J. Mechanisms of heteroresistance and resistance to imipenem in Pseudomonas aeruginosa. Infect. Drug Resist. 2020, 13, 1419. [Google Scholar] [CrossRef]

| pH of Medium before Inoculation | CFU/mL at 24 h | pH of the Medium after 24 h Incubation | Biofilm OD at 48 h | CFU/mL at 48 h | ||
|---|---|---|---|---|---|---|
| NCP (SD) | SGCP (SD) | NCP (SD) | SGCP (SD) | |||
| 4.0 | 2.7 × 102 (16.8) | 09 (1.8) | 4.2 | 0.81 | 3.1 × 103 (250) | 14 (4) |
| 5.0 | 1.8 × 104 (8.8 × 102) | 1.6 × 102 (17.7) | 5.1 | 1.09 | 7.7 × 104 (1.7 × 103) | 2.6 × 102 (21) |
| 6.0 | 9.4 × 104 (9.6 × 102) | 3.3 × 101 (6.4) | 5.3 | 0.97 | 8.1 × 104 (1.4 × 103) | 2.4 × 102 (16) |
| 7.0 | 8.6 × 105 (1.21 × 104) | 00 | 5.3 | 0.79 | 9.9 × 105 (1.6 × 104) | 3.7 × 102 (23.6) |
| 8.0 | 8.8 × 105 (1.45 × 104) | 07 (2.2) | 6.1 | 0.77 | 1.9 × 105 (1.34 × 104) | 3.9 × 102 (17.9) |
| 9.0 | 9.3 × 105 (1.0 × 104) | 06 (1.4) | 6.3 | 0.78 | 5.4 × 105 (1.44 × 104) | 4.2 × 102 (31) |
Publisher’s Note: MDPI stays neutral with regard to jurisdictional claims in published maps and institutional affiliations. |
© 2022 by the authors. Licensee MDPI, Basel, Switzerland. This article is an open access article distributed under the terms and conditions of the Creative Commons Attribution (CC BY) license (https://creativecommons.org/licenses/by/4.0/).
Share and Cite
Ahmed, F.; Mirani, Z.A.; Mirani, P.N.; Imdad, M.J.; Khan, F.Z.; Khan, M.N.; Khan, A.B.; Li, Y.; Zhao, Y. Pseudomonas aeruginosa Response to Acidic Stress and Imipenem Resistance. Appl. Sci. 2022, 12, 8357. https://doi.org/10.3390/app12168357
Ahmed F, Mirani ZA, Mirani PN, Imdad MJ, Khan FZ, Khan MN, Khan AB, Li Y, Zhao Y. Pseudomonas aeruginosa Response to Acidic Stress and Imipenem Resistance. Applied Sciences. 2022; 12(16):8357. https://doi.org/10.3390/app12168357
Chicago/Turabian StyleAhmed, Faraz, Zulfiqar Ali Mirani, Pirbhat Nadir Mirani, Muhammad Janees Imdad, Fouzia Zeeshan Khan, Muhammad Naseem Khan, Abdul Basit Khan, Yufeng Li, and Yong Zhao. 2022. "Pseudomonas aeruginosa Response to Acidic Stress and Imipenem Resistance" Applied Sciences 12, no. 16: 8357. https://doi.org/10.3390/app12168357
APA StyleAhmed, F., Mirani, Z. A., Mirani, P. N., Imdad, M. J., Khan, F. Z., Khan, M. N., Khan, A. B., Li, Y., & Zhao, Y. (2022). Pseudomonas aeruginosa Response to Acidic Stress and Imipenem Resistance. Applied Sciences, 12(16), 8357. https://doi.org/10.3390/app12168357






